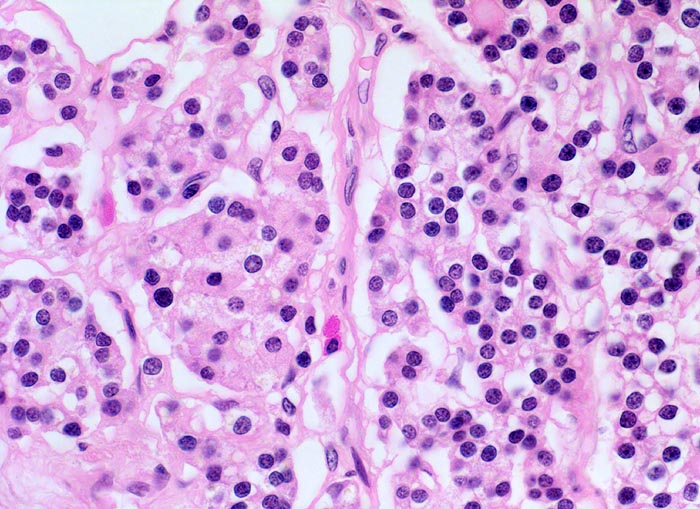

PathoPic – image database / PathoPic ID 4333 - normale Nebenschilddrüse: Hauptzellen
de
Diagnose
normale Nebenschilddrüse: Hauptzellen
Diagnose Gruppe
Normalbefund
Topographie
Nebenschilddrüse
Topographie Gruppe
Endokrinium
Beschreibung
Kommentar
Das Abschätzen der hormonellen Aktivität der Nebenschilddrüse und die Differenzierung in normal, hyperplastisch oder adenomatös aufgrund histologischer Kriterien allein ist schwierig. Drüsengrösse, Gewicht, Form und relatives Verhältnis von Fettzellen und Hauptzellen sollten bei der funktionellen Beurteilung berücksichtigt werden. Der Umstand, dass oxyphile Zellen in Adenomen und hyperplastischen Drüsen funktionell sind, nicht aber in normalen Drüsen muss berücksichtigt werden.
Bilder Typ
Histologie
Vergrösserung
400
Alter
64
Geschlecht
männlich
Datum
Ersteintrag: 05.04.2002
Update: 18.12.2006